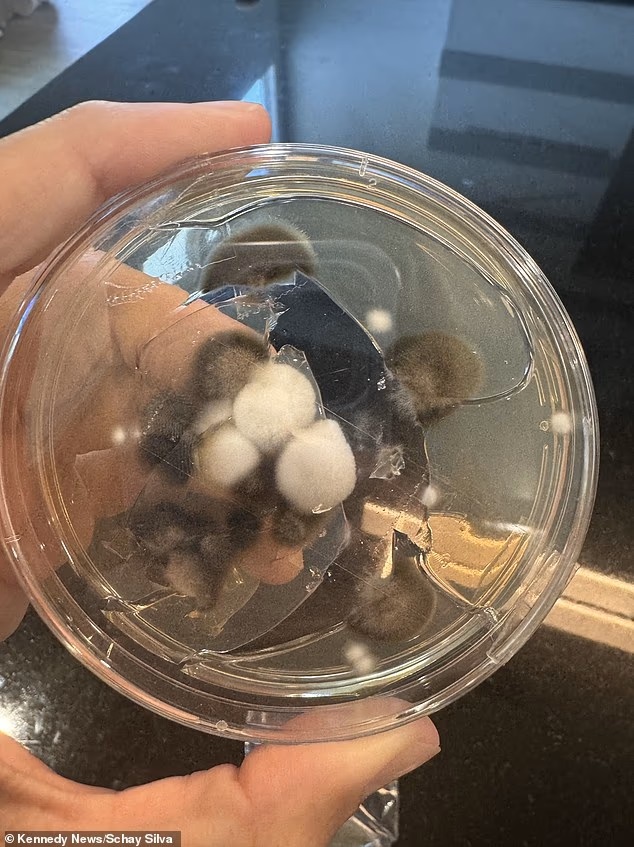

В феврале 2022 года Шайен Сильва была рада наконец-то переехать в новый дом. Однако несколько месяцев спустя у нее началась изнурительная изжога, развился хронический кашель и рвота. Женщина обратилась к врачу, который списал все на «просто газы».
Визит ко врачу не помог, и Сильва провела почти три года, посещая еще семерых врачей. Все специалисты также утверждали, что проблема связана с пищеварением. Лишь в октябре 2024 года восьмой врач наконец направил 38-летнюю Сильва на МРТ, и тогда эта жительница Оклахомы узнала истинную причину своих болей — рак.

Обследование выявило новообразование на левой почке, которое врачи определили как светлоклеточную почечную карциному первой стадии (ccRCC) — наиболее распространенный тип рака почек в США. Хотя у большинства видов рака почек точная причина неизвестна, такие привычки образа жизни, как курение и употребление алкоголя, могут приводить к повреждению ДНК, вызывающему образование опухолей. Когда Сильва объяснила врачам, что не курит и не злоупотребляет алкоголем, они сказали ей, что болезнь — это просто «невезение».
В апреле 2025-го женщине удалили опухоль хирургическим путем, но она была полна решимости найти первопричину, чтобы предотвратить рецидив. Изучив возможные причины в интернете, Сильва решила проверить свой дом на наличие плесени, которая вырабатывает токсины, связанные с повреждением органов и некоторыми формами рака. Первоначальные проверки не выявили никаких проблем, пока Шайен не решила заглянуть в льдогенератор. Разобрав внешний корпус, она обнаружила, что машина «покрыта плесенью».

Дальнейшие анализы показали, что в организме Сильва содержалось в десять раз больше охратоксина, вырабатываемого плесневыми грибами рода Aspergillus (зеленый цвет) и Penicillium (синий цвет). По данным Всемирной организации здравоохранения, наиболее заметным последствием воздействия охратоксина является повреждение почек, но он также может оказывать влияние на развитие плода и на иммунную систему.
«У меня начал болеть бок, и тогда я стала ходить к врачам. Один из них сказал, что я слишком молода для рака. Никто не воспринимал меня всерьез, пока меня не направили на МРТ и КТ», — вспоминает Сильва. Она узнала о своем диагнозе онлайн: «Я могла только плакать. Это было ужасно. Несколько недель я плакала, но потом мне пришлось взять себя в руки. Я начала проводить всевозможные исследования».
Рак почек, также называемый раком почечных артерий, ежегодно поражает около 80 000 американцев и уносит жизни 15 000 человек, что делает его седьмым по распространенности видом рака в США. Почечно-клеточный рак, который начинается в клетках, помогающих фильтровать отходы из крови, составляет примерно восемь из десяти случаев рака почек.
Это заболевание обычно поражает пожилых, средний возраст постановки диагноза составляет 65 лет. По данным Национального института рака (NCI), только 6% пациентов находятся в возрасте от 35 до 44 лет. Точные причины неясны, но все больше данных свидетельствует о том, что токсины, вырабатываемые некоторыми видами плесени, могут повышать риск.
В местах с высокой влажностью, таких как посудомоечные машины и льдогенераторы, плесени обычно достаточно одного-двух дней, чтобы начать расти, хотя для появления более очевидных признаков, таких как запахи и видимые пятна, могут потребоваться недели или месяцы. Существует несколько видов плесени, которые опаснее других. Самая опасная форма — черная плесень — вырабатывает опасные химические соединения, называемые микотоксинами, которые при многократном вдыхании вызывают когнитивные нарушения, изменения настроения, симптомы, похожие на астму, головные боли, кашель, мышечные боли и аутоиммунные реакции.
Когда организм обнаруживает токсины, такие как споры в воздухе, иммунная система запускает масштабную защиту, посылая шквал воспалительных химических веществ, называемых цитокинами, которые действуют как сигналы тревоги. Они могут распространяться по всему организму через кровоток и достигать всех органов и систем, включая эндокринную систему и головной мозг. Затем плесень вызывает воспаление, повреждает ткани и атакует жизненно важные клетки и нейроны.
Анализы Сильва, которые обычно проводятся с использованием мочи или крови, выявили охратоксин А — микотоксин, вырабатываемый зелеными и синими плесневыми грибами. Он также считается нефротоксином, то есть вызывает воспаление и гибель клеток в почках, повышая риск развития рака.
«Я была опустошена. У меня двое маленьких сыновей, поэтому я думала только о том, что умру. Когда мне делали операцию, я подумала: «Как ты думаешь, что стало причиной? Должно быть что-то одно». [Врач] сказал, что они не могут точно сказать. Он сказал: «Вероятно, это просто невезение. Я не приемлю невезение», — рассказала женщина.
После операции Сильва полностью излечилась от рака и перестала пользоваться аппаратом для приготовления льда, что, по ее словам, облегчило такие симптомы, как изжога, тошнота, выпадение волос и тревожность.
«У меня уже нет панических атак, я снова могу водить машину, у меня растут волосы и ногти. Как только вы перестаете подвергаться воздействию вредных веществ, ваш организм сам знает, как восстанавливаться. Я знала, что [врач] ошибался, поэтому не сдавалась. Я чувствую, что победила. Со мной все в порядке».
Поддержать работу блога донатом можно по ссылке.
Больше на Сто растений, которые нас убили
Подпишитесь, чтобы получать последние записи по электронной почте.
